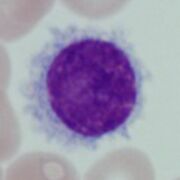
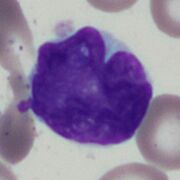
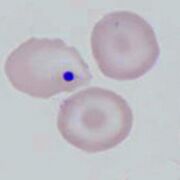
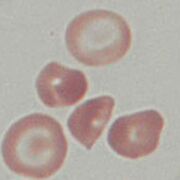
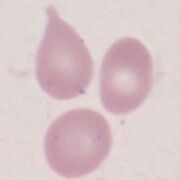

Uploads by John
This special page shows all uploaded files.
| Date | Name | Thumbnail | Size | Description | Versions |
|---|---|---|---|---|---|
| 21:15, 12 July 2023 | LPL.jpg (file) |  |
34 KB | 1 | |
| 21:15, 12 July 2023 | PC.jpg (file) |  |
30 KB | 1 | |
| 21:14, 12 July 2023 | HCL.jpg (file) | |
34 KB | 1 | |
| 21:12, 12 July 2023 | MZL.jpg (file) |  |
42 KB | 1 | |
| 21:11, 12 July 2023 | FL.jpg (file) |  |
37 KB | 1 | |
| 21:10, 12 July 2023 | MCL.jpg (file) | |
39 KB | 1 | |
| 15:15, 30 June 2023 | ManWithAbs.jpg (file) |  |
44 KB | 1 | |
| 13:22, 28 June 2023 | CLLCD45.jpg (file) |  |
83 KB | 1 | |
| 10:19, 28 June 2023 | CLL.jpg (file) |  |
24 KB | 1 | |
| 13:36, 29 March 2023 | RedCellsBack.png (file) |  |
425 KB | 1 | |
| 22:07, 28 March 2023 | PH2A.jpg (file) |  |
32 KB | 1 | |
| 22:07, 28 March 2023 | PH1A.png (file) |  |
72 KB | 1 | |
| 21:48, 28 March 2023 | BS1A.png (file) |  |
121 KB | 1 | |
| 21:34, 28 March 2023 | HJ2A.jpg (file) | |
35 KB | 1 | |
| 21:33, 28 March 2023 | HJ1A.png (file) |  |
115 KB | 1 | |
| 21:17, 28 March 2023 | HJ0.png (file) |  |
68 KB | 1 | |
| 13:15, 28 March 2023 | BS0A.png (file) |  |
83 KB | 1 | |
| 12:25, 28 March 2023 | BS0.png (file) |  |
88 KB | 1 | |
| 10:21, 28 March 2023 | Fr0.png (file) |  |
83 KB | 1 | |
| 10:12, 28 March 2023 | Ec0.png (file) |  |
91 KB | 1 | |
| 09:31, 28 March 2023 | Kt1A.png (file) |  |
121 KB | 1 | |
| 09:30, 28 March 2023 | Kt0.png (file) |  |
55 KB | 1 | |
| 17:46, 27 March 2023 | Crys0.png (file) |  |
109 KB | 1 | |
| 17:42, 27 March 2023 | Crys2B.jpg (file) |  |
38 KB | 1 | |
| 17:42, 27 March 2023 | IRC2B.png (file) |  |
109 KB | 1 | |
| 17:31, 27 March 2023 | Crys1A.png (file) |  |
76 KB | 1 | |
| 15:42, 27 March 2023 | HG0A.png (file) |  |
47 KB | 1 | |
| 15:42, 27 March 2023 | HG1A.png (file) |  |
79 KB | 1 | |
| 15:31, 27 March 2023 | St0A.png (file) |  |
52 KB | 1 | |
| 15:17, 27 March 2023 | TC1B.png (file) |  |
70 KB | 1 | |
| 15:15, 27 March 2023 | TC0.png (file) |  |
87 KB | 1 | |
| 15:12, 27 March 2023 | TC1A.png (file) |  |
87 KB | 1 | |
| 14:27, 27 March 2023 | Ova1A.png (file) |  |
154 KB | 1 | |
| 10:57, 27 March 2023 | Pen1A.png (file) |  |
90 KB | 1 | |
| 10:57, 27 March 2023 | Pen0.png (file) |  |
59 KB | 1 | |
| 10:49, 27 March 2023 | Ova0.png (file) |  |
78 KB | 1 | |
| 10:39, 27 March 2023 | MSp0A.png (file) |  |
94 KB | 1 | |
| 10:35, 27 March 2023 | MSp0.jpg (file) |  |
39 KB | 1 | |
| 23:33, 26 March 2023 | SP2A.jpg (file) |  |
37 KB | 1 | |
| 23:28, 26 March 2023 | SP0.png (file) |  |
110 KB | 1 | |
| 23:19, 26 March 2023 | Ellip1A.png (file) |  |
132 KB | 1 | |
| 23:07, 26 March 2023 | Ellip0.png (file) |  |
59 KB | 1 | |
| 23:04, 26 March 2023 | Boat0.png (file) |  |
60 KB | 1 | |
| 23:01, 26 March 2023 | Boat2A.png (file) |  |
79 KB | 1 | |
| 22:03, 26 March 2023 | IRC1A.png (file) |  |
51 KB | 1 | |
| 22:00, 26 March 2023 | IRC2A.png (file) |  |
101 KB | 1 | |
| 21:59, 26 March 2023 | IRC2A.jpg (file) | |
34 KB | 1 | |
| 21:40, 26 March 2023 | SCP0.png (file) |  |
44 KB | 1 | |
| 21:32, 26 March 2023 | TD2A.jpg (file) | |
45 KB | 1 | |
| 21:25, 26 March 2023 | TD0.png (file) |  |
65 KB | 1 |